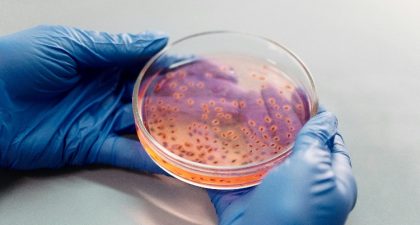

Chile es uno de los principales exportadores de Gracilaria chilensis, alga roja esencial para la producción de agar. Sin embargo, en los cultivos estas algas casi no se reproducen sexualmente y dependen de la propagación clonal, lo que limita su diversidad genética.
bacterias
ADL presentó avances en Piscirickettsiosis durante jornada científica, destacando investigación, diagnósticos y desarrollo de vacunas para salmonicultura.
Investigación de la UCSC explora el uso de microorganismos en celdas de combustible microbianas para generar energía renovable.
Investigadores aislaron y caracterizaron del agua de cultivo de una piscicultura con peces con flavobacteriosis una nueva especie bacteriana, la cual fue bautizada como Flavobacterium psychraquaticum.
El extracto de Andrographis paniculata demostró efecto antibacteriano contra P. salmonis, lo que podría reducir el uso de antibióticos en la acuicultura.
Protec Gill es la solución nutricional de Skretting Chile, destinada a recuperar la funcionalidad branquial de los peces, tras eventos ambientales desafiantes.
Protec Gill es la solución nutricional de Skretting Chile, destinada a recuperar la funcionalidad branquial de los peces, tras eventos ambientales desafiantes.
El encuentro, que busca exponer los avances tecnológicos asociados al cultivo de peces marinos nativos en un contexto de cambio climático.
Workshop «Perspectivas Multidisciplinarias sobre RAM y Antibióticos en la Acuicultura» reunió a especialistas en acuicultura, salud pública y medio ambiente.
Investigadores descubren sistemas de adquisición de hierro en patógeno de peces, Tenacibaculum dicentrarchi, clave para su patogenicidad y relevante a nivel mundial.